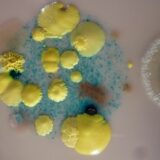

Kageprint: En moderne måde at personliggøre desserter på


Kageprint er blevet en utrolig populær metode til at tilføje et personligt præg på kager og desserter. Om det er til børnefødselsdage, bryllupper, jubilæer eller en anden særlig begivenhed, kan et kageprint gøre en stor forskel og efterlade et varigt indtryk. Denne artikel udforsker hvad kageprint er, hvordan det bruges, og hvilke muligheder der findes for dem, der ønsker at give deres bagværk det ekstra pift, som kun et personligt billede eller design kan give.
Hvad er kageprint?
Kageprint, også kendt som spiseligt print eller spiselige billeder, er en teknologi, der bruger fødevaregodkendte blæk til at printe billeder eller designs direkte på kageoverflader, fondant, marcipan, eller specielle spiselige papirarter kendt som vaffel- eller sukkerpapir. Teknikken er ikke kun begrænset til fotos alt fra personlige beskeder til komplekse grafiske designs kan transformeres til en spiselig realitet.
Teknologien bag kageprint involverer ofte brug af en speciel printer, der er designet eller tilpasset til at håndtere spiseligt blæk og papir. Det spiselige blæk er lavet af fødevarefarver, hvilket betyder, at det er helt sikkert at spise. Resultatet er et klart, skarpt print, der kan gøre enhver kage unik og mindeværdig.

Anvendelse af kageprint i bagværk
Kageprint anvendes på mange forskellige måder, afhængigt af begivenheden og kundens præferencer. For eksempel kan man vælge at printe et billede af brudeparret på en bryllupskage, en tegnefilmskarakter på et barns fødselsdagskage eller måske et firma logo til en virksomhedsbegivenhed, hvilket både er professionelt og opsigtsvækkende.
At anvende kageprint er relativt enkelt. Man starter med at vælge det ønskede billede, hvorefter dette tilpasses kagestørrelsen og printes på spiseligt papir. Herefter overfører man forsigtigt printet til kagen, og med den rette omhu og teknik, smelter det spiselige billede elegant sammen med overfladen af kagen. Vigtigst af alt kræver dette ingen avancerede bagefærdigheder – enhver kan dekorere en kage med et kageprint.
Kreative ideer og tendenser indenfor kageprint
Kreativiteten grænser ikke ved et almindelig foto eller logo. Mange bagerier og hjemmebagere eksperimenterer med forskelligartet kageprint, herunder forskellige teksturer som blonder eller træ, der efterligner andre materialer. Udover flade billeder oplever man også en tendens til at skabe 3D-effekter med printede elementer, som kan bruges til at bygge op og skabe mere komplekse designs.
For dem, der søger at fejre sæsonbestemte begivenheder, kan kageprint også være en fantastisk mulighed. Fra halloween monsterbilleder til julenisse og snefnugdesigns, himlen er grænsen. Tematiske kageprints kan gøre hvert eneste stykke bagværk til en festlig oplevelse.
Fordele ved at bruge kageprint
En stor fordel ved at bruge kageprint er dets tilgængelighed og brugervenlighed. Man behøver ikke længere at tage et kursus i avanceret kagedekoration for at skabe imponerende og professionelt udseende kager. Derudover sparer det tid i forhold til traditionel dekoration, hvilket kan være særligt nyttigt, når man skal håndtere store ordremængder eller stramme deadlines.
Desuden gør kageprint det muligt at personalisere kagen på et meget mere detaljeret niveau, end man normalt kunne opnå med hånden. Dette giver bageren mulighed for at tilbyde en service, der kan tilpasses til næsten enhver kundes ønsker og behov.
I lysten til at udforske kageprint, er det værd at søge professionel ekspertise for at opnå de bedste resultater. Et dansk firma som Cakeprint.dk specialiserer sig i spiselige prints til enhver anledning og tilbyder et bredt udvalg af muligheder for dem, der gerne vil personliggøre deres kager. Deres brugervenlige service og høje kvalitetsprint sikrer, at din næste kage bliver så personlig og mindeværdig, som den kan blive.
Kageprint er ikke blot en sjov og innovativ tilføjelse til bagværksdekoration; det er også et værktøj, der kan bringe fantasifulde ideer til live på en nem og overkommelig måde. Uanset om du er professionel bager eller bageentusiast, er potentialet for at personliggøre med kageprint næsten uendeligt, og resultaterne er altid imponerende.